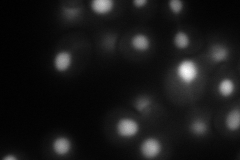
YPR133C

View description
Protein that interacts with Spt6p and copurifies with Spt5p and RNA polymerase II, probable transcriptional elongation factor; metazoan homologs contain an acidic N terminus; mutations in the gene confer an Spt- phenotype
Localization:
Intensity:
Fold change:
Significance:
-
C’ GFP library in SD

nucleus53.22 -
N' NOP1pr-GFP in SD

nucleus,nucleolus134.744 -
N' TEF2pr-mCherry in SD
nucleus135.088 -
N' NATIVEpr-GFP in SD

nucleus71.7764 -
N' TEF2pr-VC and Cyto-VN in SD

#N/A0 -
C’ GFP library in SD+DTT

nucleus65.721.23No -
C’ GFP library in SD+H2O2

nucleus65.391.22No -
C’ GFP library in Starvation Media

nucleus65.751.23No -
C’ GFP library on the background of Pup2-DaMP

nucleus -
C’ GFP library on the background of CCT mutant

nucleus61.01111.14613No
